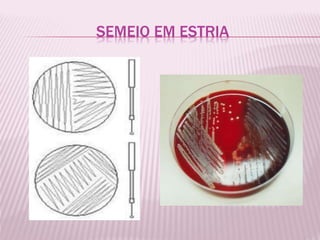
SEMEIO EM ESTRIA
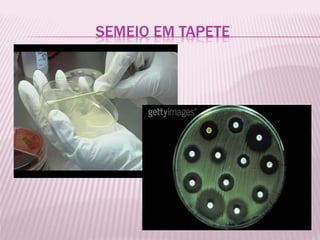
SEMEIO EM TAPETE

Incorporar apresentação
Baixado 76 vezes




























O documento fornece uma revisão sobre instrumentos e técnicas microbiológicas utilizadas no laboratório, incluindo alças, swabs, pinças, placas de Petri, tubos de ensaio, autoclave, centrífuga e a coloração de Gram. A técnica da coloração de Gram é descrita em detalhes, envolvendo o uso de cristal violeta, iodo, álcool e safranina para diferenciar bactérias Gram-positivas e Gram-negativas sob o microscópio.